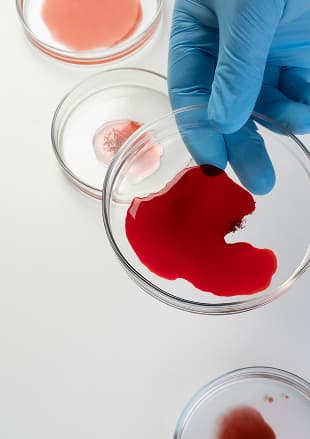
Histopathology and tissue examination

Our Lab Services Department provides accurate and timely testing to support diagnosis and treatment.
The department offers a wide range of laboratory tests, including clinical biochemistry, microbiology and serology, hematology, histopathology, and general pathology. Every test is conducted with careful attention to safety and quality standards. Patients are guided through the process, ensuring they understand each step and feel comfortable.
Our experienced laboratory specialists analyze every sample with precision. Detailed reports are shared with the treating doctors to support accurate diagnosis and effective treatment planning. The team collaborates closely with clinical departments to ensure results are timely and actionable.
Quality control is a constant focus for our team. Regular checks and equipment calibration help maintain reliability and accuracy for every test. This commitment ensures that patients and doctors can trust the findings and make informed decisions.
Patient education is central to the department's approach. Individuals are informed about why tests are needed and what the results mean. Clear explanations help patients understand their health and actively participate in their care.
Follow-up support is available for patients who need additional guidance or repeated testing. Staff are ready to answer questions and provide guidance, helping reduce anxiety and improve the overall experience.
Coordination with other specialties enhances patient care. Lab results support cardiology, neurology, general medicine, and surgical teams among others. This integrated approach ensures comprehensive evaluation and informed treatment decisions.
What tests are offered in Lab Services?
+How accurate are the results?
+How is patient comfort ensured during sample collection?
+Are the results shared with treating doctors?
+